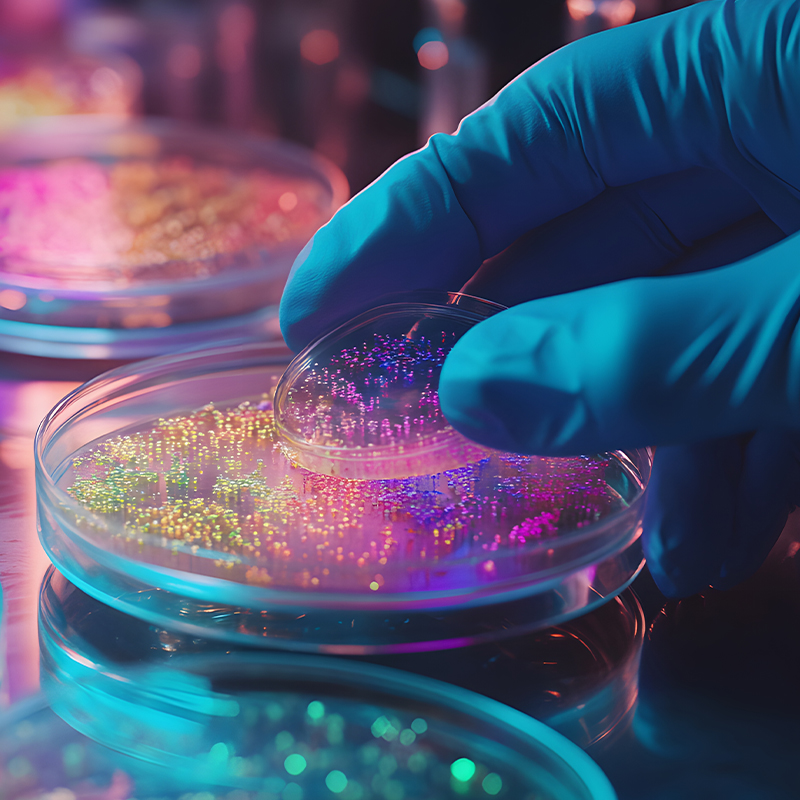

Fórmulas propias con más de 100 opciones de limpieza
Contamos con fórmulas testeadas y comprobadas de más de 100 productos de limpieza que van desde productos básicos de limpieza, hasta soluciones especializadas para la industria de diversos ramos.
Tecnología y procedimientos que aseguran la calidad de nuestros productos
Nuestros productos cumplen con rigurosas pruebas de calidad para comprobar que nuestras fórmulas no pierdan la calidad bajo diversas circunstancias extremas.

Más de 45 años de experiencia
Más de 45 años en la fabricación y comercialización de productos de limpieza nos respaldan.
